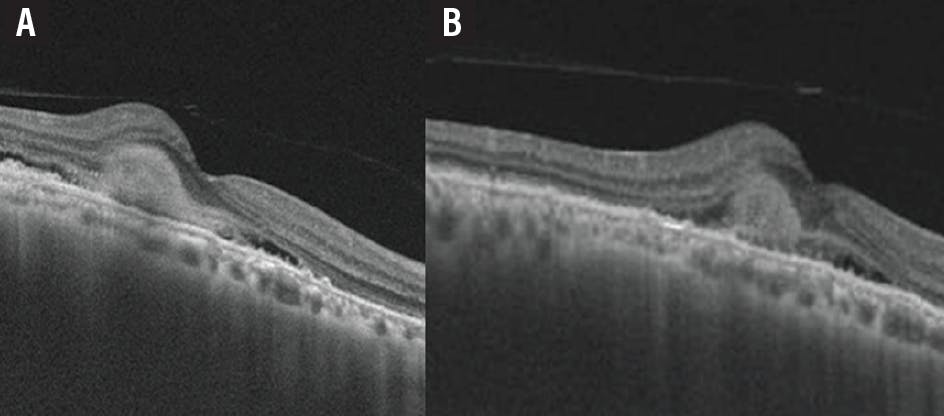
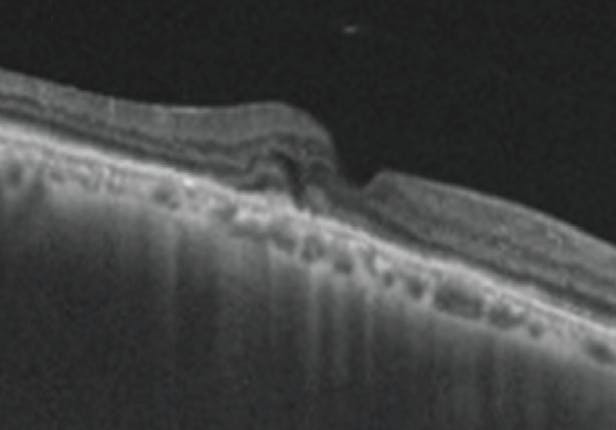
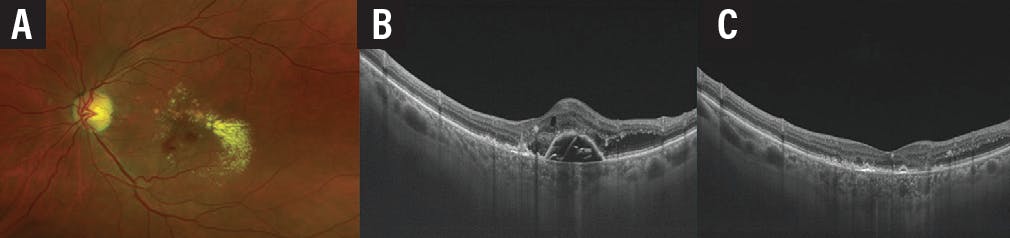
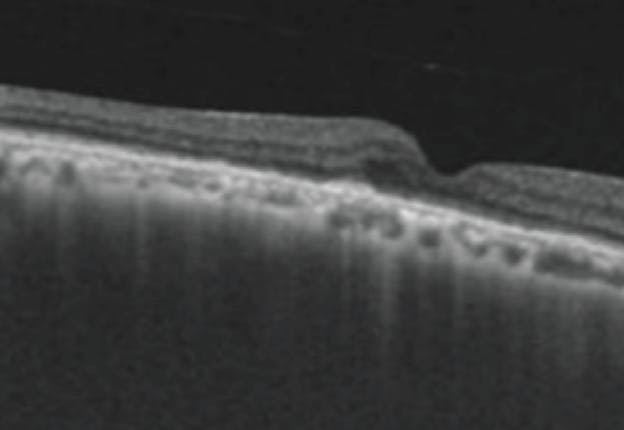
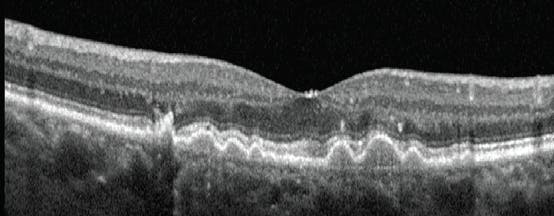

AAO 2020 Highlight
These cases were presented at the AAO 2020 Virtual Meeting, as part of the “Challenging Cases in Neovascular AMD” session. Attendees walked away with a better understanding of the possible mechanisms at work and the suitable treatment strategy for each case.
- Luiz Lima, MD, session moderator
TOUGH CASE NO. 1
By Sumit Randhir Singh, MD, and Jay Chhablani, MD
A 69-year-old man presented to the retina clinic with sudden onset loss of vision in the right eye for 1 month. Fundus examination revealed multiple small, hard drusen at the macula in each eye with subretinal hemorrhage at the fovea in the right eye. Swept-source OCT showed the presence of retinal thickening, subretinal hyperreflective material (SHRM)—including subretinal hyperereflective exudation and choroidal neovascular complex—subretinal fluid (SRF), and a shallow fibrovascular pigment epithelial detachment (PED) suggestive of type 2 choroidal neovascularization (CNV) (Figure 1A). OCT angiography (OCTA) of the right eye showed a neovascular net in the outer retina and choriocapillaris.
Figure 1. The patient’s OCT shows the presence of type 2 CNV and SHRM (A). After two intravitreal injections of ranibizumab and one of IVZ, OCT showed persistent SHRM (B).
The patient received two intravitreal injections of ranibizumab 0.5 mg/0.05 mL (Lucentis, Genentech) at baseline and at 1 month, along with one intravitreal injection of ziv-aflibercept 1.25 mg/0.05 mL (IVZ; Zaltrap, Sanofi) at the end of the second month.
At the 3-month follow-up visit, OCT imaging showed a minimum reduction of the SRF with the persistence of SHRM (Figure 1B).
See below for our approach.
TOUGH CASE NO. 2
By Julia Farah Agi, MD, and Michel Eid Farah, MD, PhD
A 65-year-old white woman presented with blurry vision in the right eye for 5 months. At presentation, her VA was 20/400 OD and 20/25 OS. The fundoscopic examination of the right eye showed macular thickening with multiple hard exudates in a circinated pattern (Figure 2A). OCT revealed a PED with SRF and intraretinal thickening in the right eye (Figure 2B). There was a disrupted retinal pigment epithelium (RPE) line at the apex, suggesting a communicating vessel. Fluorescein angiography (FA) and ICG angiography of the right eye demonstrated a vertically diving retinal vessel with retina-retina anastomosis (Figure 3).

Figure 2. The fundus image of the right eye at presentation (A). The OCT of the right eye at presentation shows a disrupted retinal pigment epithelium (arrow, B).

Figure 3. FA and ICG angiography of the right eye showed a vertically diving retinal vessel with retina–retina anastomosis.
The fundus images and OCT of the left eye showed drusenoid PEDs with intraretinal fluid (Figure 4). FA of the left eye demonstrated a poorly demarcated area of leakage (Figure 5).

Figure 4. Fundus imaging of the left eye at presentation (A) and the corresponding OCT of the left eye at presentation (B).

Figure 5. FA and ICG angiography of the left eye revealed a poorly demarcated area of leakage (arrows).
Considering the clinical picture and the multimodal analysis, a diagnosis of retinal angiomatous proliferation (RAP) was established for both eyes.
See below for our approach.
TOUGH CASE NO. 3
By Aneesha Kalur, BA, and Rishi P. Singh, MD
A 79-year-old woman presented to the retina clinic in February 2011 with a complaint of gradually decreasing vision in her right eye over the past month. Her medical history included long-standing poor vision in the left eye. BCVA was 20/25-2 OD and counting fingers OS. Ocular history of the left eye showed a hemorrhagic retinal picture with blood and scarring present within the macula. ICG angiography of the right eye showed a hyperfluorescent spot near the optic disc that corresponded with a PED and polypoidal lesions on OCT imaging.
The physician diagnosed the patient with polypoidal choroidal vasculopathy (PCV).
See below for our approach.
CASE NO. 1 TREATMENT
Given the persistence of SHRM on OCT, a combination therapy of IVZ and intravitreal triamcinolone acetonide 2 mg/0.05 mL (IVTA) was initiated.
At the 4-month follow-up, 1 month after the combination therapy, intraretinal fluid (IRF), SRF, and SHRM completely disappered and the patient was observed (Figure 6). At month 6, there was complete resolution of IRF, SRF, and SHRM with thinning of the fovea without any recurrence during this period or subfoveal scarring (Figure 7). OCTA of the right eye showed near resolution of the neovascular net. BCVA improved from 20/125 at baseline to 20/60 at month 6.
Figure 6. One month after the patient received a combination of IVTA and IVZ, there was reduction of SHRM with no IRF/SRF.
Although combining anti-VEGF agents with intravitreal steroids has not been shown to have superior results to anti-VEGF monotherapy in wet AMD,1 adding an intravitreal steroid may help to reduce or resolve SHRM and avoid subretinal scarring, as was the case for this patient.2
CASE NO. 2 TREATMENT
After being diagnosed with RAP in each eye, the patient received three intravitreal injections of aflibercept (Eylea, Regeneron) in the right eye followed by a prn regimen; the left eye received only one injection of aflibercept (Figure 8).
The follow-up showed resolution of the retinal fluid and the serous component of the PED; however, a subretinal fibrosis developed in the right eye with partial improvement of VA to 20/200 OD (Figure 9).
After 2 years of observation the patient complained of new onset of vision decline in the left eye. She presented with hard circinated exudates and retinal hemorrhage. OCT revealed reactivation of the RAP lesion. There was intraretinal and subretinal serous fluid, in addition to a significant PED. Three monthly aflibercept injections were performed, and the patient showed significant anatomic response soon after the first injection with improvement of VA to 20/25 OS (Figure 10).
Figure 10. Fundus imaging (A) and OCT 2 years after presentation (B) show exudation in the left eye. OCT imaging after three intravitreal injections of aflibercept shows marked improvements (C).
CASE NO. 3 TREATMENT
This patient with PCV began treatment with an intravitreal injection of ranibizumab in the right eye, followed by photodynamic therapy (PDT) 1 week later, as recommended in the EVEREST II study.3
At the 1-month follow-up, BCVA was 20/20 OD, and the patient reported alleviated symptoms. Over the course of 1.5 years, the patient received six doses of ranibizumab and no further PDT. Her vision was subjectively stable at 20/20-1 OD. The patient received a seventh ranibizumab injection and a second treatment of PDT in September 2013, after which the provider switched to aflibercept injections.
The most recent follow-up in March 2017 showed a BCVA of 20/20 OD. At this point, the patient had received 13 doses of aflibercept, the most recent one given in December 2016. OCT showed no abnormalities at this follow-up.
1. Riazi-Esfahani M, Ahmadieh H, Faghihi H, et al. Intravitreal bevacizumab versus combined bevacizumab and triamcinolone acetonide for neovascular age-related macular degeneration. J Ophthalmic Vis Res. 2008;3(2):95-101.
2. Yang S, Zhao J, Sun X. Resistance to anti-VEGF therapy in neovascular age-related macular degeneration: a comprehensive review. Drug Des Devel Ther. 2016;10:1857-1867.
3. Koh A, Lai TYY, Takahashi K, et al; the EVEREST II study group. Efficacy and safety of ranibizumab with or without verteporfin photodynamic therapy for polypoidal choroidal vasculopathy a randomized clinical trial. JAMA Ophthalmol. 2017;135(11):1206-1213.
How to Diagnose and Manage RPE Rips in the Setting of AMD
By Amani Fawzi, MD
A rip in the RPE can occur during the course of neovascular AMD therapy, usually in eyes with a vascularized PED or those with type 1 CNV, where it has been reported spontaneously in approximately 10% of eyes. The risk is considered much higher in eyes in which the PED has a large basal diameter or tall PEDs (> 600 µm on OCT poses an approximate 30% risk). A hyperfluorescent ring or halo surrounding a PED on FA may be a telltale sign of an impending RPE rip.1
Treatment is generally successful in these eyes, although the sudden development of an RPE rip may be associated with drastic visual consequences when the central fovea is involved. Eyes with high-risk characteristics are at risk for the spontaneous development of an RPE rip, and the risk has been reported to be slightly higher during anti-VEGF therapy. The pathogenesis is thought to be related to contraction of the sub-RPE neovascular tissue, creating tangential stress on the overlying RPE.2
One of the main prognostic factors for the visual outcome is the location of the rip; small rips that do not involve the fovea may be associated with excellent vision.1-3
An important dilemma that clinicians face is whether to continue therapy once an RPE rip occurs. The widely accepted approach is to continue therapy if there is evidence of ongoing lesion activity, particularly in eyes in which the fovea is preserved.1
1. Sarraf D, Joseph A, Rahimy E. Retinal pigment epithelial tears in the era of intravitreal pharmacotherapy: risk factors, pathogenesis, prognosis and treatment (an American Ophthalmological Society thesis). Trans Am Ophthalmol Soc. 2014;112:142-159.
2. Nagiel A, Freund KB, Spaide RF, Munch IC, Larsen M, Sarraf D. Mechanism of retinal pigment epithelium tear formation following intravitreal anti-vascular endothelial growth factor therapy revealed by spectral-domain optical coherence tomography. Am J Ophthalmol. 2013;156(5):981-988.e2.
3. Invernizzi A, Nguyen V, Arnold A, Young S, Barthelmes D, Gillies MC. Early and late retinal pigment epithelium tears after anti–vascular endothelial growth factor therapy for neovascular age-related macular degeneration. Ophthalmology. 2018;125(2):237-244.
Amani Fawzi, MD
Professor of Ophthalmology, Northwestern University Feinberg School of Medicine, Chicago
afawzimd@gmail.com
Financial disclosure: Regeneron, Boehringer Ingelheim, Genentech/Roche